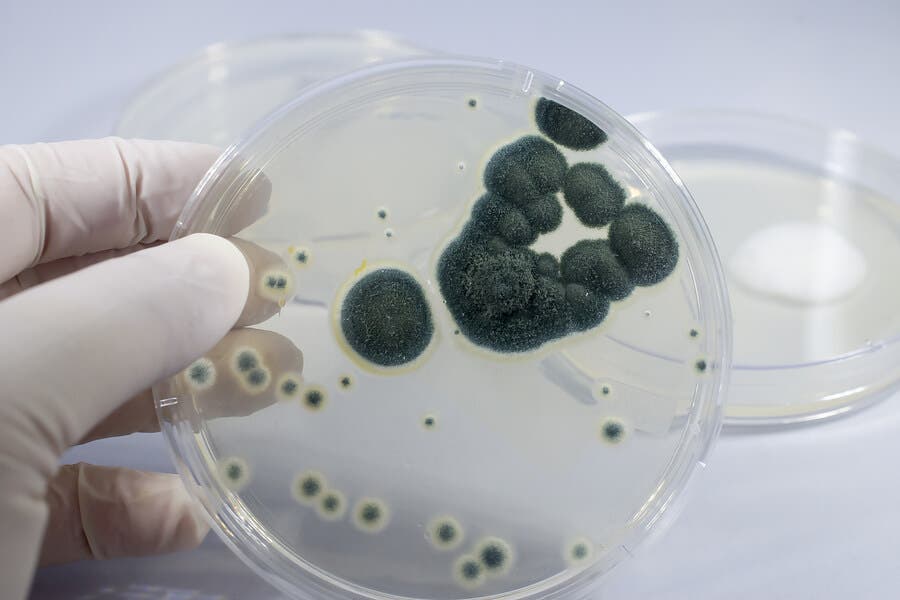
Some figure

¿Qué es y para qué sirve la penicilina?


Revisado y aprobado por el médico Diego Pereira
La penicilina es un medicamento antibiótico derivado del hongo Penicillium. Este gran descubrimiento en el mundo de la medicina hay que agradecérselo al científico Alexander Fleming, un especialista británico en el campo de la bacteriología.
Este científico descubrió la penicilina en el año 1928. Sin embargo, no se pudo producir a gran escala hasta pasados otros 10 años. Quienes se encargaron de esta tarea fueron, entre otros profesionales, el bioquímico Ernst Boris y el patólogo Howard Florey.
La penicilina es un antibiótico que pertenece a la familia de los betalactámicos (β-lactámicos). Es un antibacteriano con un amplio espectro de acción, siendo efectiva frente a muchas y diferentes bacterias, tales como los neumococos, los estreptococos, el Clostridium tetani (desencadenante del tétanos) o los meningococos, entre otros.
Decimos que ha sido una gran revelación en el mundo de la medicina porque, cuando se descubrió, se consiguió erradicar un gran número de enfermedades que estaban resultando mortales para los pacientes de aquella época, como por ejemplo la septicemia, la gonorrea o la escarlatina.
Sin embargo, se ha abusado considerablemente de la administración tanto de la penicilina como de los derivados sintéticos y semisintéticos que se han ido descubriendo con el tiempo. Como consecuencia de ello, las bacterias se han vuelto resistentes a estos tratamientos.
Este hecho supone un grave problema para la salud mundial. Hoy en día se siguen investigando nuevos mecanismos de acción y nuevas alternativas terapéuticas para combatir estas bacterias resistentes.
La penicilina pertenece a la familia de los betalactámicos (β-lactámicos). Su descubrimiento representó un hecho de gran relevancia para la medicina.
¿Qué son los antibióticos betalactámicos?

En general, estos antibióticos son de espectro reducido, ya que solo son eficaces frente a bacterias gram positivas (aunque la penicilina es de amplio espectro) y son bactericidas, es decir, provocan la muerte del microorganismo.
Son fármacos que se administran por vía oral y parenteral. Además, son muy seguros, ya que las posibles reacciones adversas se limitan a posibles reacciones de hipersensibilidad. No obstante, estas reacciones hay que tenerlas controladas, pues pueden llegar a producir un shock anafiláctico.
Por otra parte, a pesar de que pueden atravesar la barrera placentaria, sí que se pueden administrar a mujeres embarazadas por el buen perfil de seguridad que se han demostrado en los ensayos clínicos.
Son antibióticos utilizados de una manera muy amplia, y entre los grupos que forman esta familia de antibióticos podemos encontrar:
- Penicilinas.
- Cefalosporinas.
- Carbapenémicos.
- Monobactámicos: activos frente a bacterias gram negativas.
Mecanismo de acción: ¿cómo desencadena la penicilina el efecto en el organismo?
La penicilina es un fármaco que mata e inhibe el crecimiento de las bacterias. Por esta razón, está considerado como un fármaco bactericida. Además, solo puede erradicar los microorganismos que están creciendo y multiplicándose, no a los que se encuentran en estado de latencia.
Por otra parte, y tal y como hemos comentado, la penicilina pertenece al grupo de los antibióticos β-lactámicos. Esta familia de fármacos, para conseguir el objetivo terapéutico en las enfermedades bacterianas, es capaz de inhibir la síntesis de la pared celular bacteriana, estructura imprescindible para la vida de las bacterias.
Para ello, inhiben el proceso de transpeptidación y, en definitiva, impiden la síntesis de peptidoglicano, que es la sustancia mayoritaria de la pared celular de las bacterias. Para lograr este fin, el antibiótico debe penetrar en el interior de la célula y, una vez allí, se une a las proteínas fijadoras de penicilinas.
Lee también: Metabolismo hepático: antibióticos y alcohol
Reacciones adversas: alergia a la penicilina
La penicilina, a pesar de presentar un buen perfil de seguridad, puede producir una serie de efectos adversos. Entre ellos, cabe destacar la reacción de hipersensibilidad o alergia a la penicilina. Es el efecto adverso más importante, aunque la gravedad varía de un paciente a otro. Los síntomas incluyen:
- Urticaria.
- Shock anafiláctico.
- Erupciones cutáneas pasajeras.
Otras reacciones que se pueden desencadenar con el tratamiento con este medicamento son trastornos gastrointestinales tales como diarrea, náusea y vómitos.
Descubre: Antibióticos: ¿es necesario tomar un protector de estómago?
El descubrimiento de la penicilina ha sido un gran avance en la medicina. Gracias a este medicamento se han podido erradicar muchas enfermedades mortales en aquella época. Sin embargo, el abuso tan marcado que se hizo de este medicamento, así como de los demás descubrimientos, provocó el desarrollo de resistencias por parte de las bacterias.
Por lo anterior, estos antibióticos han perdido considerablemente la eficacia y, por tanto, se ha hecho necesario el descubrimiento de nuevos agentes terapéuticos.
Todas las fuentes citadas fueron revisadas a profundidad por nuestro equipo, para asegurar su calidad, confiabilidad, vigencia y validez. La bibliografía de este artículo fue considerada confiable y de precisión académica o científica.
- Ligon, B. L. (2004). Penicillin: Its Discovery and Early Development. Seminars in Pediatric Infectious Diseases, 15(1), 52–57. https://doi.org/10.1053/j.spid.2004.02.001
- Kardos, N., & Demain, A. L. (2011, November). Penicillin: The medicine with the greatest impact on therapeutic outcomes. Applied Microbiology and Biotechnology. https://doi.org/10.1007/s00253-011-3587-6
- Lobanovska, M., & Pilla, G. (2017). Penicillin’s discovery and antibiotic resistance: Lessons for the future? Yale Journal of Biology and Medicine, 90(1), 135–145.
- Gaynes, R. (2017). The discovery of penicillin—new insights after more than 75 years of clinical use. Emerging Infectious Diseases, 23(5), 849–853. https://doi.org/10.3201/eid2305.161556
- Macy, E. (2018). Penicillins. In Drug Allergy Testing (pp. 103–113). Elsevier Inc. https://doi.org/10.1016/B978-0-323-48551-7.00010-9
Este texto se ofrece únicamente con propósitos informativos y no reemplaza la consulta con un profesional. Ante dudas, consulta a tu especialista.







